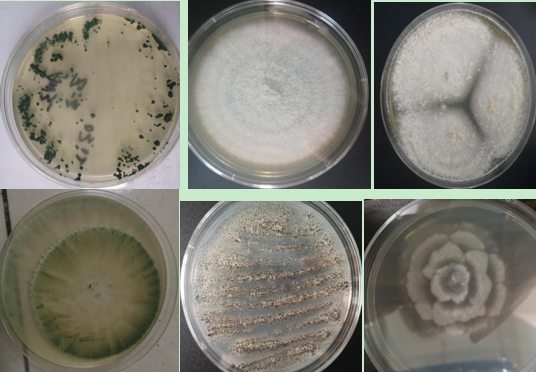
50人大型联合科考队,破解"世界长寿之乡生态圈"微生物密码!

链霉菌平板

50人大型联合科考队,破解"世界长寿之乡生态圈"微生物密码!
图片尺寸536x372
vsf弗氏链霉菌——强菌之路!
图片尺寸640x242
一株阿洛杰链霉菌bc1及其应用
图片尺寸1046x1031
白色链霉菌
图片尺寸400x300
湘坪链霉菌
图片尺寸300x300
一种链霉菌及其在防治甘蔗凤梨病中的应用
图片尺寸604x604
石垣链霉菌
图片尺寸268x268
链霉菌的形态,构造模式图
图片尺寸1151x732
金色链霉菌
图片尺寸268x178
天蓝色链霉菌
图片尺寸250x300【现学现卖】链霉菌防治禾谷作物病原镰刀菌(1)
图片尺寸512x371
产色链霉菌
图片尺寸576x430
链霉菌的各种孢子丝形态
图片尺寸1165x1079
链霉菌
图片尺寸606x464
蓝色链霉菌,来源:twitter
图片尺寸1080x743
热蓝紫链霉菌(菌种)
图片尺寸580x773
多色链霉菌
图片尺寸293x220
链霉菌是真核还是原核
图片尺寸800x320
氧载体和金属离子对褐黄孢链霉菌发酵的影响
图片尺寸600x450
绿孢链霉菌形貌
图片尺寸945x463

(1).png)





